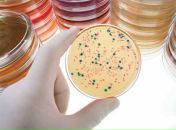
Фотография

Кого добавила в друзья и на кого подписалась Татьяна Вайцель. Новые подписчики.
Обновляем изменения в друзьях...
Теперь изменения в списке друзей будут отслеживаться. Каждый раз при посещении этой страницы будет происходить повторная проверка.Для оперативного получения новой информации добавьте эту страницу в закладки. (На компьютере Ctrl+D)